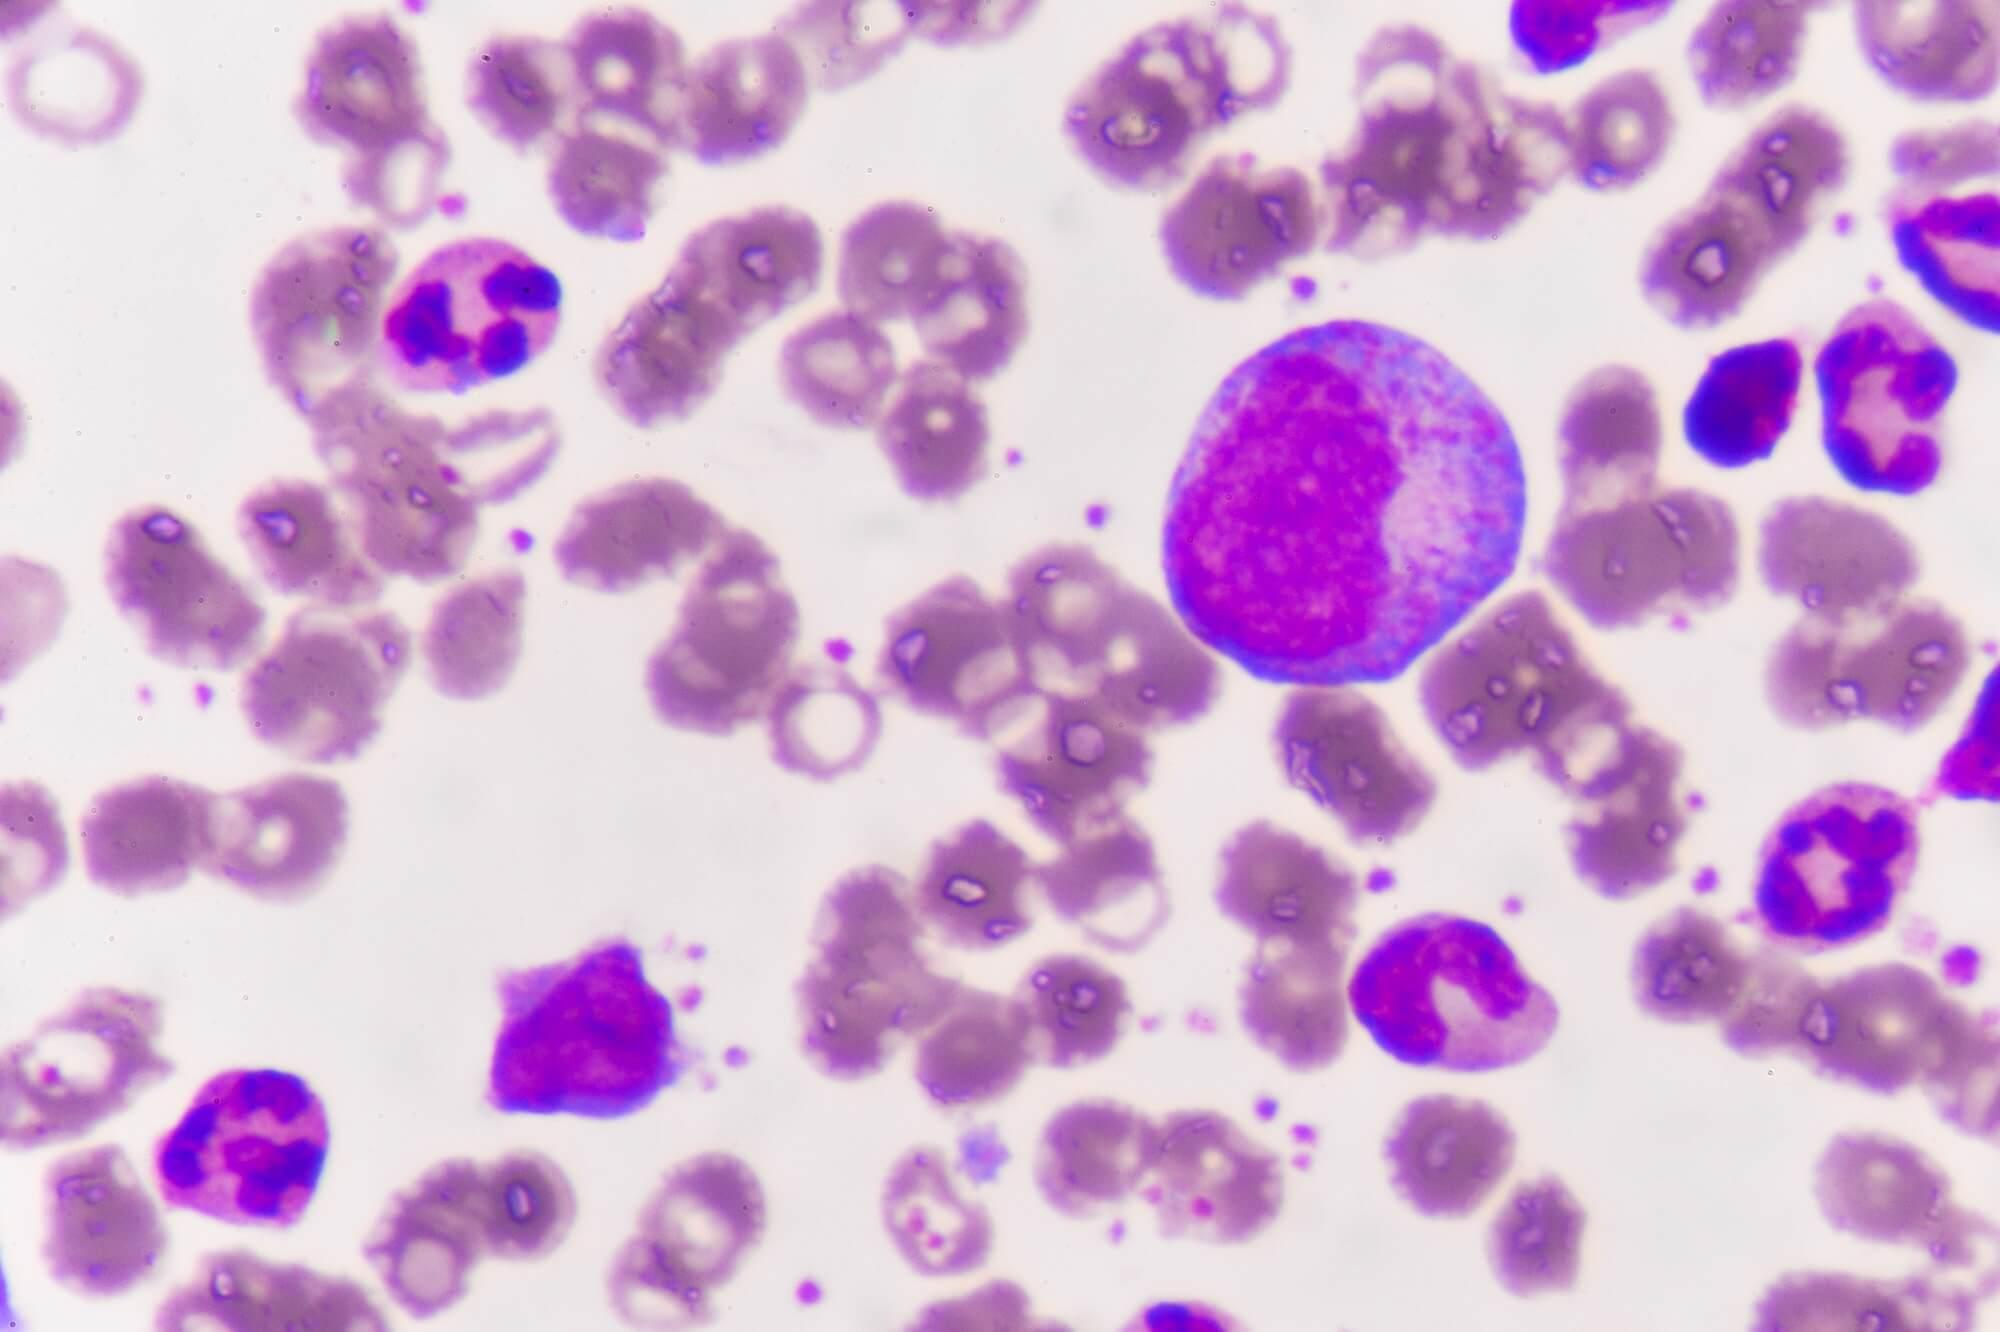

血液淋巴細胞數量增加,懷疑患有「慢性淋巴細胞白血病」(Chronic lymphocytic leukaemia),骨髓穿刺有助確診。治療前為血液或骨髓內的癌細胞進行「基因分析」(Genetic analysis)有助評估病者預後,可用「染色體檢查」(Cytogenetic study)及「熒光原位雜交」技術(Fluorescence In Situ Hybridization, FISH)。同時接受「正電子掃描」(Positron Emission Tomography)或全身「電腦掃描」(Computerised Tomography),可清楚顯示病者全身器官受影響的情況。
多種標靶藥物及化療藥物可有效控制「慢性淋巴白血病」,包括「單克隆抗體」(Monoclonal antibody):「利妥昔單抗」(Rituximab)及「阿托珠單抗」(Obinutuzumab),又有「布魯頓酪氨酸激酶抑制劑」(Briton kinase inhibitor)「依羅替尼」(Ibrutinib)及「阿卡替尼」(Acalabrutinib),還有「bcl-2抑制劑」(Venetoclax);傳統化療藥物有「環磷酰胺」(Cyclophosphamide)及「氟達拉濱」(Fludarabine),還有新一代的化療藥物「苯達莫司汀」(Bendamustine)。醫生一般選擇同時處方兩種藥物,可增療效。
「慢性淋巴細胞白血病」病情一般發展緩慢,早期患者或不需要馬上接受治療。「異體血幹細胞移植」(Allogeneic haematopoietic stem cell transplant)乃唯一根治療法,個別較年輕患者可考慮,但要小心移植手術的風險。
















